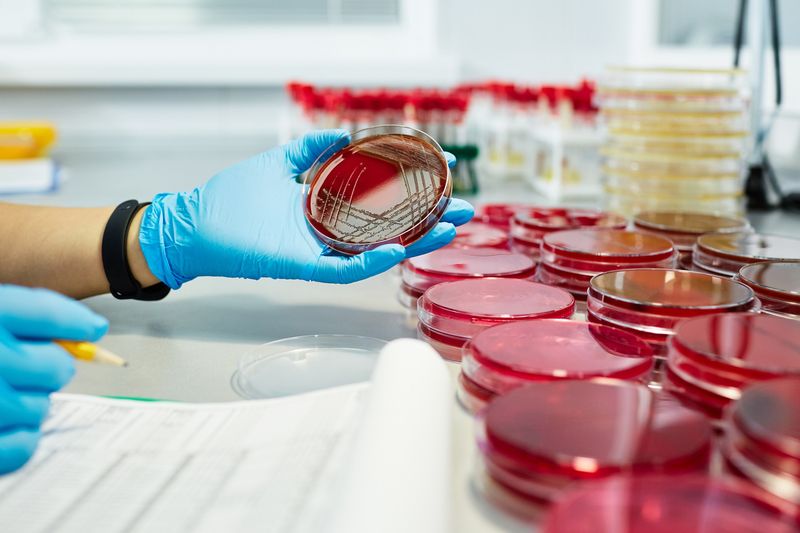

06
Список
литературы
Клинические рекомендации "Кандидоз новорождённых". Разработчики: Общероссийская общественная организация содействия развитию неонатологии «Российское общество неонатологов» (РОН), Общественная организация «Российская ассоциация специалистов перинатальной медицины» (РАСПМ). — Утверждено: Минздав РФ. МКБ-10: P37.5. Возрастная категория: дети. — 2025. https://raspm.ru/files/kandidoz.pdf
Клинические рекомендации "Урогенитальный кандидоз". Разработчики: Российское общество дерматовенерологов и косметологов. Уровни убедительности рекомендаций А-С (уровни достоверности доказательств 1++, 2++). Рекомендации по диагностике, лечению натамицином, флуконазолом и поддерживающей терапии рецидивирующего кандидоза. https://medi.ru/klinicheskie-rekomendatsii/urogenitalnyj-kandidoz_14319/
Centers for Disease Control and Prevention (CDC). Vulvovaginal Candidiasis. Sexually Transmitted Infections Treatment Guidelines. — 2021. — Обновлено: 2026-02-10. https://www.cdc.gov/std/treatment-guidelines/candidiasis.htm
Eckert L.O., Lenowitz J.L. Vulvovaginal Candidiasis: A Review of the Evidence for the 2021 Centers for Disease Control and Prevention of Sexually Transmitted Infections Treatment Guidelines // Clinical Infectious Diseases. — 2022. — Vol. 74, Supplement 2. — P. S162–S173. DOI: 10.1093/cid/ciab1063. https://academic.oup.com/cid/article/74/Supplement_2/S162/6567950
Raja A. Oral Candidiasis // StatPearls [Internet]. StatPearls Publishing. — 2023. — Обновлено: 04.07.2023. https://www.ncbi.nlm.nih.gov/books/NBK545282/ https://www.ncbi.nlm.nih.gov/books/NBK545282/
Hidalgo J.A., Bronze M.S. Candidiasis Guidelines. Infectious Diseases Society of America (IDSA) Guidelines // Medscape/eMedicine. — Обновлено: 24.03.2023. https://emedicine.medscape.com/article/213853-guidelines